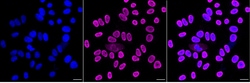
Invitrogen hnRNP U Recombinant Rabbit Monoclonal Antibody (23GB6350), Invitrogen

missing translation for 'onlineSavingsMsg'
Learn More
Learn More
Invitrogen™ hnRNP U Recombinant Rabbit Monoclonal Antibody (23GB6350), Invitrogen™
Rabbit Recombinant Monoclonal Antibody
Brand: Invitrogen™ MA553025
This item is not returnable.
View return policy
Description
The protein encoded by this gene is a receptor for activated C-kinase (RACK) protein. The encoded protein has been shown to bind in vitro to activated protein kinase C beta I. In addition, this protein is a cutaneous T-cell lymphoma-associated antigen. Finally, the protein contains a bromodomain and two zinc fingers, and is thought to be a transcriptional regulator. Multiple transcript variants encoding several different isoforms have been found for this gene.
Specifications
| hnRNP U | |
| Recombinant Monoclonal | |
| 0.33 mg/mL | |
| PBS with 50% glycerol and 0.02% sodium azide; pH 7.4 | |
| Q00839, Q8VEK3 | |
| Hnrnpu | |
| A synthesized peptide derived from human hnRNP U (50-100AA). | |
| 20 μL | |
| Primary | |
| Human, Mouse, Rat | |
| Antibody | |
| IgG |
| Flow Cytometry, Western Blot, Immunocytochemistry | |
| 23GB6350 | |
| Unconjugated | |
| Hnrnpu | |
| AA408410; AI256620; AL024194; AL024437; AW557595; C1orf199; C86794; FLJ30202; FLJ37978; GRIP120; Heterogeneous nuclear ribonucleoprotein U; heterogeneous nuclear ribonucleoprotein U (scaffold attachment factor A); heterogenous nuclear ribonucleoprotein U; hnRNP U; HNRNPU; HNRNPU antisense RNA 1; HNRNPU-AS1; Hnrpu; NCRNA00201; nuclear matrix protein sp120; Nuclear p120 ribonucleoprotein; p120; p120 nuclear protein; pp120; rCG_20317; SAFA; SAF-A; scaffold attachment factor A; Scaffold-attachment factor A; SN1; SP120; system N1 Na+ and H+-coupled glutamine transporter; transporter protein; transporter protein; system N1 Na+ and H+-coupled glutamine transporter; U21.1; U211 | |
| Rabbit | |
| Affinity chromatography | |
| RUO | |
| 117280, 3192, 51810 | |
| -20°C | |
| Liquid |
Product Content Correction
Your input is important to us. Please complete this form to provide feedback related to the content on this product.
Product Title
Spot an opportunity for improvement?Share a Content Correction